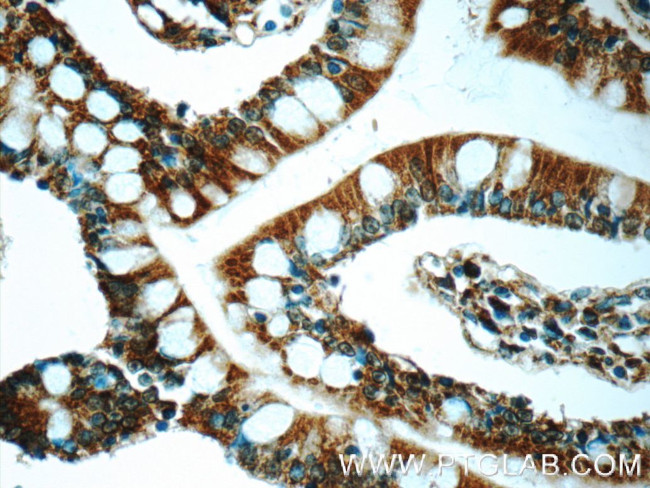
iPLA2 Antibody in Immunohistochemistry (Paraffin) (IHC (P))

Search
Proteintech
iPLA2 Polyclonal Antibody
{{$productOrderCtrl.translations['antibody.pdp.commerceCard.promotion.promotions']}}
{{$productOrderCtrl.translations['antibody.pdp.commerceCard.promotion.viewpromo']}}
{{$productOrderCtrl.translations['antibody.pdp.commerceCard.promotion.promocode']}}: {{promo.promoCode}} {{promo.promoTitle}} {{promo.promoDescription}}. {{$productOrderCtrl.translations['antibody.pdp.commerceCard.promotion.learnmore']}}
产品信息
22030-1-AP
种属反应
已发表种属
宿主/亚型
分类
类型
抗原
偶联物
形式
浓度
规格
纯化类型
保存液
内含物
保存条件
运输条件
产品详细信息
Immunogen sequence: MQFFGRLVN TFSGVTNLFS NPFRVKEVAV ADYTSSDRVR EEGQLILFQN TPNRTWDCVL VNPRNSQSGF RLFQLELEAD ALVNFHQYSS QLLPFYESSP QVLHTEVLQH LTDLIRNHPS WSVAHLAVEL GIRECFHHSR IISCANCAEN EEGCTPLHLA CRKGDGEILV ELVQYCHTQM DVTDYKGETV FHYAVQGDNS QVLQLLGRNA VAGLNQVNNQ GLTPLHLACQ LGKQEMVRVL LLCNARCNIM GPNGYPIHSA MKFSQKGCAE MIISMDSSQI HSKDPRYGAS PLHWAKNAEM ARMLLKRGCN VNSTSSAGNT ALHVAVMRNR FDCAIVLLTH GANA (1-343 aa encoded by BC036742)
靶标信息
The protein encoded by this gene is an A2 phospholipase, a class of enzyme that catalyzes the release of fatty acids from phospholipids. The encoded protein may play a role in phospholipid remodelling, arachidonic acid release, leukotriene and prostaglandin synthesis, fas-mediated apoptosis, and transmembrane ion flux in glucose-stimulated B-cells. Several transcript variants encoding multiple isoforms have been described, but the full-length nature of only two of them have been determined to date.
仅用于科研。不用于诊断过程。未经明确授权不得转售。
生物信息学
蛋白别名: 2-lysophosphatidylcholine acylhydrolase; 85 kDa calcium-independent phospholipase A2; 85/88 kDa calcium-independent phospholipase A2; CaI-PLA2; Group VI phospholipase A2; GVI PLA2; Intracellular membrane-associated calcium-independent phospholipase A2 beta; iPLA2; iPLA2-beta; neurodegeneration with brain iron accumulation 2; Palmitoyl-CoA hydrolase; Patatin-like phospholipase domain-containing protein 9; phospholipase A2, group VI (cytosolic, calcium-independent); PLA2G6; PNPLA9; unnamed protein product
基因别名: BB112799; CaI-PLA2; GVI; INAD1; iPLA(2)beta; iPLA2; IPLA2-VIA; iPLA2beta; NBIA2; NBIA2A; NBIA2B; PARK14; PLA2; PLA2G6; PLPLA9; PNPLA9
UniProt ID: (Human) O60733, (Mouse) P97819
Entrez Gene ID: (Human) 8398, (Mouse) 53357